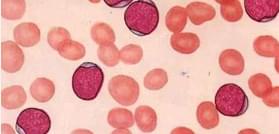

正常情况下,精子和卵子在输卵管结合成受精卵,由输卵管迁移到子宫腔发育成胎儿。如果受精卵在迁移中没能到达子宫,而是在别的地方停留,这就成了宫外孕,又称异位妊娠。90%以上宫外孕发生在输卵管。这样的受精卵不但不能发育成正常胎儿,还会像定时炸弹一样引发危险。
炎症可以造成输卵管粘连扭曲或管腔狭窄,使得受精卵从输卵管运送至宫腔途中发生阻碍。

输卵管发育不良、畸形,也不易使受精卵顺利到达宫腔,从而引发异位妊娠的情况发生。

阴道出血 有不规则阴道出血,色黯红,量少,一般不超过月经量
停经 多数宫外孕患者在发病前有短暂的停经史,多有6~8周停经


昏厥、休克 腹腔急性内出血及剧烈腹痛,轻者出现晕厥,严重出现失血性休克
腹痛 常为突发性下腹一侧有撕裂样或阵发性疼痛,并伴恶心呕吐


 详细咨询专家有关宫外孕的危害>>>
详细咨询专家有关宫外孕的危害>>>

 定量检查 尿HCG早孕检查
定量检查 尿HCG早孕检查 通过检测尿液中是否含有HCG,来判断是否怀孕。宫外孕患者体内的尿HCG水平较正常妊娠时低,故一般的尿HCG测定方法,阳性率较低。
 定量检查 彩色B超检查
定量检查 彩色B超检查 早期输卵管妊娠时,B超显像可见子宫增大,但宫腔空虚,宫旁有低回声区。用超声检测孕囊和胎心搏动对诊断异位妊娠十分重要,妊娠囊位于宫外,即可诊断为宫外妊娠。


 定量检查 血HCG早孕检查
定量检查 血HCG早孕检查 对于宫外孕疑似者,医生建议做血HCG早孕检查。通过血液“定量”检查其准确率在99%。血HCG检查比孕酮检测宫外孕更精确。


腹腔镜可以在不牵动腹腔脏器的前提下从不同角度和方向检查,达到直观检查效果,无漏诊,无误诊。

微诊疗手术无需缝合,3毫米手术创口,术后创可贴覆盖即可。手术创口隐蔽而微小,术后不留疤痕。

手术不开刀,时间短,出血少。手术当天可以下床活动,术后第一天可以进食,术后第三天可以出院。

先进微诊疗手术,取胚不开刀,有效保留女性输卵管,保障再孕能力,为下次妊娠奠定一个好基础。

 案例回顾
案例回顾
我院腔镜手术团队正在为宫外孕患者实施手术
2016年12月28日,晚上八点左右,一位宫外孕患者被紧急送到杭州红房子妇产医院。当时患者出现急腹痛、出血症状,情况危急。考虑到患者年纪轻、未生育,专家组决定采用腹腔镜微创取胚术,可以完整保留输卵管、保障生育;微创伤口小,不影响腹部美观。手术顺利,患者术后恢复良好,一周内出院。


应用空气洁净技术,通过建立科学的人、物流程及严格的分层管理,达到控制微粒、感染,保证手术安全的目的。控制空气洁净度满足各类手术的要求;并提供适宜温度、湿度,创造一个洁净舒适的手术空间环境。







受邀参加北大妇科高端学术会议
荣膺“国际妇科微创新技术推广定点单位”
“全国宫颈喦防治工程定点医院”











本站是医患沟通平台,患者自述病情所发表的言论仅供参考,不能作为诊断和治疗的直接依据,具体请遵照经治医师意见。